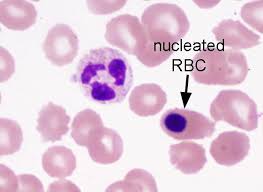
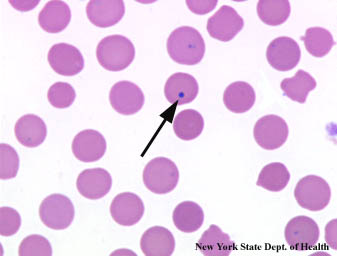
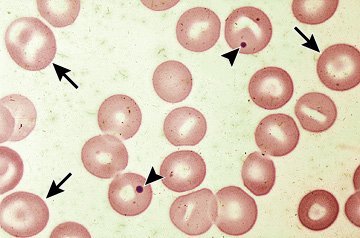
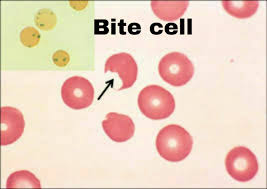
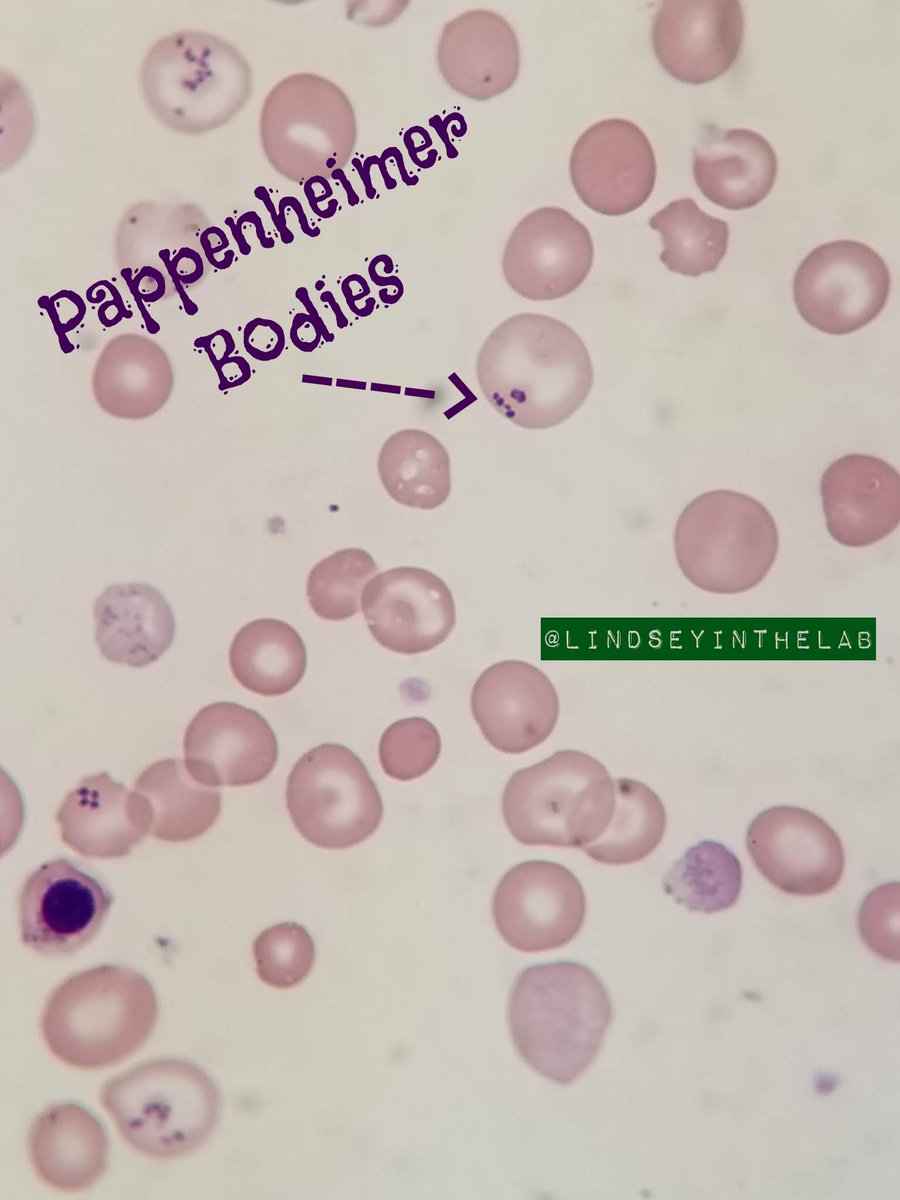
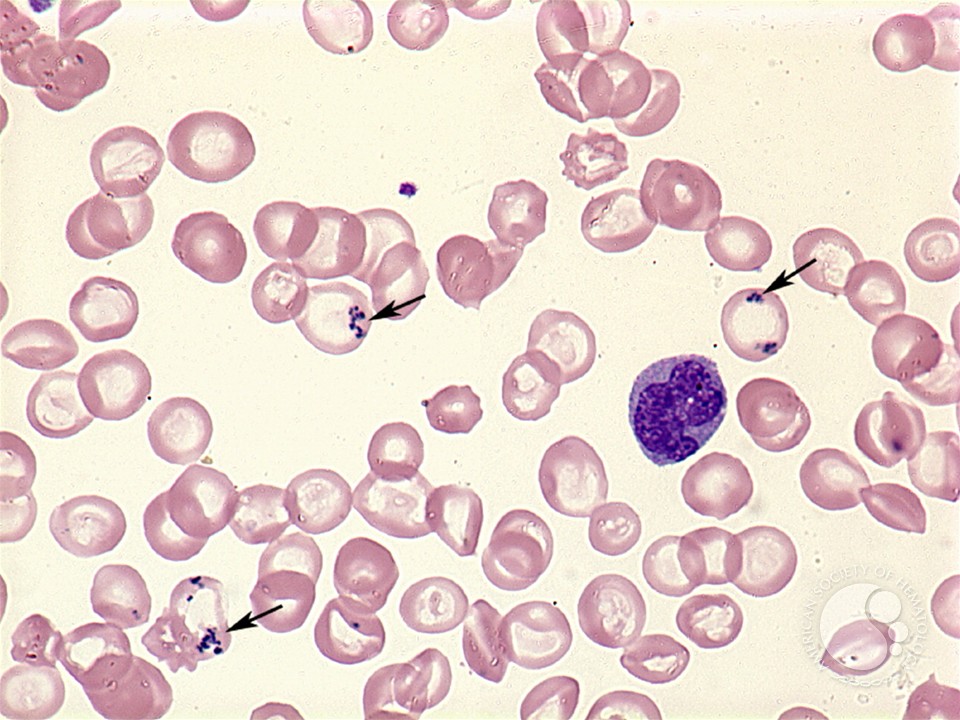
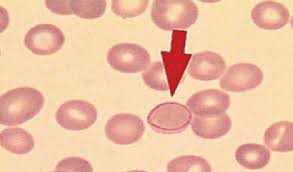
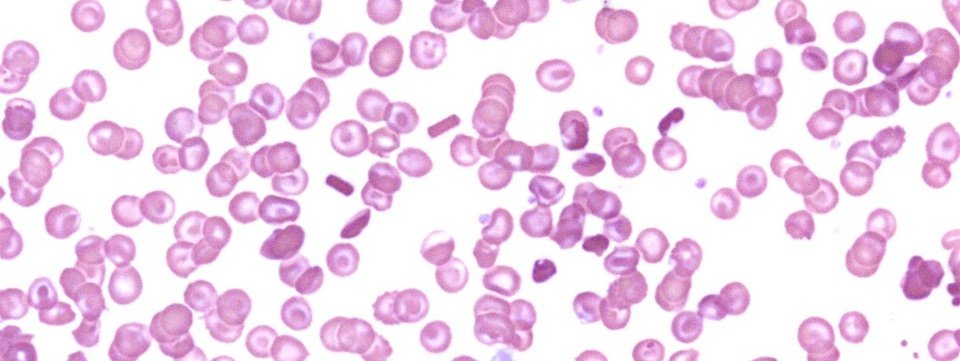
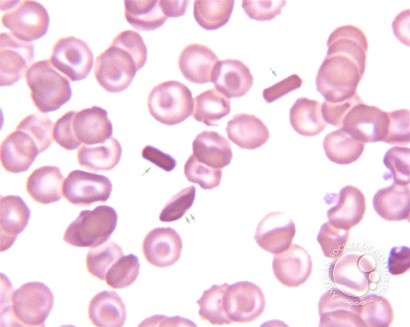

الحالات الي ممكن تحفز نخاع العظم ينتج خلايا دم حمراء بنواة(نونو 👶🏻⭕) ⬇️
📌 Thalassemia major
📌 sickle cell anemia
📌 hemolytic anemias
📌 erythroleukemia
📌 myeloproliferative disorders
الاطفال حديثي الولاده ممكن نلاقي عندهم عدد قليل منها
بس بالنسبه لشخص بالغ وسليم ولاوحده‼️
📌 Thalassemia major
📌 sickle cell anemia
📌 hemolytic anemias
📌 erythroleukemia
📌 myeloproliferative disorders
الاطفال حديثي الولاده ممكن نلاقي عندهم عدد قليل منها
بس بالنسبه لشخص بالغ وسليم ولاوحده‼️
تكون موجودة في هذي الحالات ⬇️
📌 sickle cell anemia
📌 beta-thalassemia major
📌 megaloblastic anemia
📌 alcoholism
📌 post-splenectomy
📌 sickle cell anemia
📌 beta-thalassemia major
📌 megaloblastic anemia
📌 alcoholism
📌 post-splenectomy
نشوفها لما يكون المريض مصاب ب...
📌 Thalassemias
📌 Megaloblastic anemias
📌 Sideroblastic anemia
📌 Leadpoisoning
📌 Alcoholism
📌 Thalassemias
📌 Megaloblastic anemias
📌 Sideroblastic anemia
📌 Leadpoisoning
📌 Alcoholism
راح نشوفها في الحالات هذي ⬇️
📌 Sideroblastic anemia
📌 Hemoglobinopathies
📌 Thalassemia
📌 Megaloblastic anemia
📌 Myelodysplastic syndrome (RARS)
📌 Sideroblastic anemia
📌 Hemoglobinopathies
📌 Thalassemia
📌 Megaloblastic anemia
📌 Myelodysplastic syndrome (RARS)
نلاقيه في ⬇️
📌 Megaloblastic anemia
📌 Myelodysplastic syndromes
📌 Lead poisoning
📌 Megaloblastic anemia
📌 Myelodysplastic syndromes
📌 Lead poisoning
تكون موجوده في حاله كان المريض مصاب ب
📌G6PD deficiency
📌beta-thalassemia major
📌Hgb H disease
📌unstablehemoglobinopathies
📌drug-induced anemias
📌G6PD deficiency
📌beta-thalassemia major
📌Hgb H disease
📌unstablehemoglobinopathies
📌drug-induced anemias
جاري تحميل الاقتراحات...